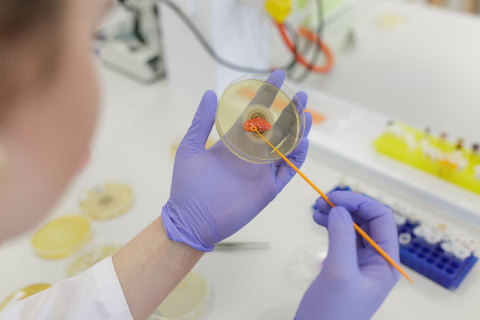
Jedna osoba w laboratorium trzyma w dłoniach szklaną płytkę Petriego. Na dłoniach ma fioletowe rękawiczki. Osoba dotyka powierzchni pożywki pomarańczowym wymazakiem. W tle widać białe blaty, żółte i niebieskie stojaki oraz elementy aparatury laboratoryjnej.

Stypendia ministra zdrowia otrzymali:
- Nicole Maria Akpang
- Adrian Norbert Bednarek
- Krzysztof Tomasz Bieliński
- Barbara Anna Buchalska
- Mateusz Aleksander Gotowiec
- Igor Piotr Jaszczyszyn
- Kamil Krauz
- Jakub Krzysztof Kwiatkowski
- Franciszek Ługowski
- Michał Grzegorz Majewski
- Maja Emilia Owe-Larsson
- Karol Sadowski
- Karol Artur Sadowski
- Jaromir Bartosz Tomasik
- Jakub Michał Zimodro
Jak wypadliśmy na tle innych uczelni
W tym roku ograniczono liczbę przyznawanych stypendiów do 40, przy jednoczesnym zwiększeniu wysokości świadczenia do 22.000 zł. Wprowadzona zmiana służy docenieniu najzdolniejszych studentów, ich promocji w środowisku akademickim i zachęceniu do pracy naukowo-badawczej w dziedzinie medycyny i ochrony zdrowia.
Do ministra wpłynęło 120 wniosków o przyznanie stypendium na rok akademicki 2025/2026. Wnioski zostały ocenione przez ekspertów zespołu doradczego powołanego przez ministra zdrowia.
Laureaci reprezentowali osiem uczelni medycznych. Pod względem liczby nagrodzonych osób WUM zajął pierwsze miejsce. Z Uniwersytetu Medycznego w Katowicach stypendia otrzymało 6 osób; z Uniwersytetu Medycznego w Łodzi - 5 osób; z Gdańskiego Uniwersytetu Medycznego - 4 osoby; z Uniwersytetu Medycznego im. Piastów Śląskich we Wrocławiu – 4 osoby; z Uniwersytet Medyczny w Lublinie – 3 osoby; z Uniwersytetu Medycznego w Białymstoku – 2 osoby; z Uniwersytetu Medycznego w Poznaniu – 1 osoba.
Strona z informacjami o wszystkich laureatach stypendium